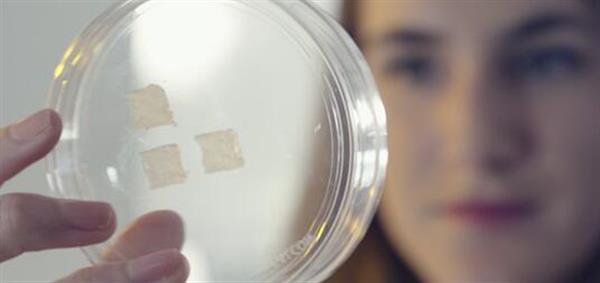

日前,中国化妆品企业伽蓝集团JALA成功利用3D生物打印生产出亚洲人皮肤,成为一家利用3D生物打印技术打印出亚洲人皮肤的企业,并用于化妆品测试。
LabSkin Creations近年来开发了一项独特的利用3D生物打印来体外重建皮肤组织的技术(专利技术)。五年前,伽蓝集团启动了“3D皮肤细胞模型”项目,在摩根博士带领下,与法国皮肤实验室LabSkin Creations合作,终于用3D生物打印机成功打印出亚洲人的皮肤,成功使用中国人来源的皮肤细胞构建3D生物打印皮肤。这将对针对亚洲消费者的皮肤需求、开发测试更先进安全的化妆品产品起到了重要推动作用。

东方人的肌肤和西方人的肌肤,从人种到皮肤结构和肌理,都是有差异的,而所有的后天影响因素,比如饮食、环境、空气污染、以及东方人不喜欢暴露于阳光下的习惯都会影响到皮肤的特性。拥有了生物打印皮肤这种体外三维结构的有机体,就可以利用它做更多的研发,包括原料功能测试、化妆品功效评估、药物开发,以及各种各样推动生物技术发展的机理性研究。

只需要21天,就能打造出一块具有完整结构和功能的皮肤组织,通过体外3D培养技术,可以成功构建含有表皮、真皮和DEJ基底膜的完整结构的皮肤组织模型,与正常人体皮肤接近,具有皮肤的三维结构。3D生物打印机遵照设计好的程序,再现外观和成分都高度近似于真实皮肤的人工皮肤。
实现3D生物打印的关键是“生物墨水”,它的成分由LabSkin Creations实验室历经数年研究而发现,并获得了专利。“生物墨水”由很多成分组成,其中很重要的一个就是皮肤干细胞,伽蓝在3D生物打印中使用的就是亚洲人的皮肤干细胞。在生物打印过程中,打印机喷嘴在电脑程序的指挥下,左右或上下移动实现精确的定位,把包裹着皮肤干细胞的生物墨水打印出来,从而实现定位打印皮肤细胞、叠加成层。整个打印过程只需要1分56秒,一块具有三维结构的皮肤原型就形成了,该皮肤模型再经过21天的精心培养成熟,就可以得到外观、成分和功能都高度近似于真实皮肤的人工皮肤。生物打印技术成功地将常规皮肤细胞模型培养的时间缩短了一半之长,其三个关键特性是:精准、快速和高仿真。
无独有偶,生物打印公司Organovo在2016年就宣布了与化妆品巨头欧莱雅(美国)的一项合作。Organovo会将NovoGen 生物打印机投入合作,而欧莱雅将会投入皮肤细胞技术。双方在产品研发、测试、制造、评估和销售非处方的护肤产品及保健品领域建立有效合作。
除了3D打印皮肤用于化妆品测试,3D科学谷认为值得注意的是国外国内还出现了3D打印皮肤用于烧伤治疗,多伦多大学的生物医学和机械工程研究生团队还发明了PrintAlive 3D生物打印机,能够使用患者自身的细胞制造人造皮肤移植物,避免皮肤移植的所有不良后果。国内第三军医大学西南医院烧伤研究所所长吴军和他的研究团队在进行通过3D打印皮肤来覆盖烧伤患者患处的研究工作。
整理综合自:中新网
网络投稿:editor@51shape.com